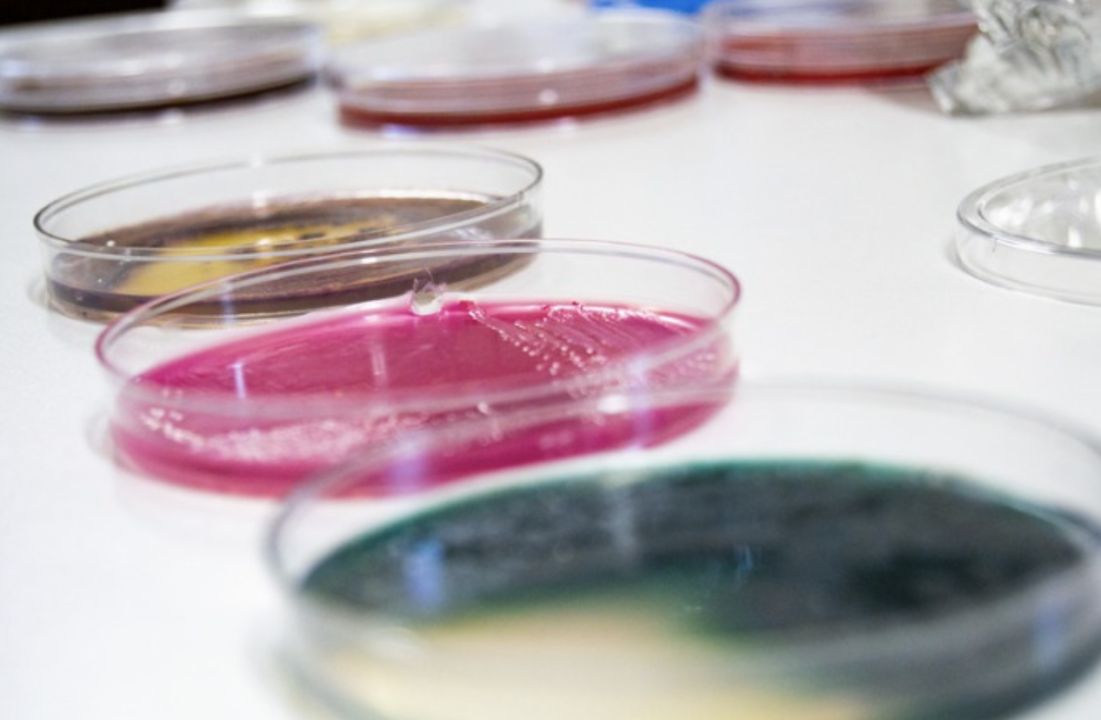

Investigadores de Bariloche lograron bajar los microorganismos contaminantes en la cerveza artesanal
Estos microorganismos aumentan la acidez, los aromas y generan sabores no deseados. Con controles y capacitación, la situación mejoró en los últimos siete años.
Un grupo de científicos integrantes del Ipatec (Instituto Andino Patagónico de Tecnologías Biológicas y Geoambientales) detectó una baja de microorganismos contaminantes en las cervezas artesanales. El estudio se realizó en 15 cervecerías artesanales de Río Negro y Chubut que emplean la levadura patagónica Euby.
La ciencia profundiza su alianza con la cerveza
Los investigadores del instituto que depende del Conicet y la Universidad Nacional del Comahue reiteraron los primeros meses de este año los análisis microbiológicos que realizaron en 2015.
«Los resultados preliminares indican que la situación a nivel microbiológico ha mejorado notablemente respecto a la incidencia en general. La cantidad de microorganismos bajó al 50% contra el 80% que se había registrado en 2015″, especificó Diego Libkind, director del Ipatec.
Los análisis, indicó, permiten mejorar la calidad ya que los productores que presentan esta problemática pueden solicitar asistencia técnica por parte del instituto para buscar las causas e implementar soluciones.
Este doctor en Bioquímica detalló que la cerveza se elabora principalmente con agua, malta de cebada, lúpulo y levaduras cerveceras encargadas de la fermentación alcohólica. «La presencia de otros microorganismos, como bacterias o levaduras no cerveceras (denominadas salvajes), puede comprometer notoriamente las características sensoriales del producto, como el aumento de acidez, aromas y sabores no deseados», dijo.
Aclaró que estos contaminantes, por lo general, no son dañinos para la salud «siempre y cuando las cervezas cumplan con las especificaciones del Código Alimentario Argentino respecto del ph y el contenido mínimo de alcohol».

El primer trabajo de investigación se llevó a cabo en 75 cervezas artesanales embotelladas provenientes de 37 cervecerías de 12 localidades andinas, desde el norte de Neuquén a Tierra del Fuego en 2015. Fue la primera vez que se realizó un trabajo de estas características en el país por parte de investigadores del Ipatec y Probien. Además, fue publicado en la Revista Argentina de Microbiología.
Con esas muestras se realizaron estudios físico-químicos, microbiológicos y sensoriales a fin de identificar genéticamente los microorganismos. En esa oportunidad, los resultados indicaron que de cada 10 fábricas estudiadas, 8 presentaban algún tipo de problemas de contaminación con microorganismos. La bacteria Levilactobacillus brevis y la levadura Saccharomyces cerevisiae fueron los principales contaminantes identificados.
Fue el puntapié para que el Centro de Referencia de Levaduras y Tecnología Cervecera del Ipatec comenzara a trabajar con la Asociación de Cerveceros Artesanales de Bariloche y Zona Andina. Con financiamiento del Ministerio de Producción de Nación se aportó equipamiento a 11 productores que, a la vez, fueron entrenados en controles de calidad en fábrica. También se realizaron numerosas capacitaciones a productores sobre la temática en las cinco provincias patagónicas y en el resto del país en el marco del programa Ciencia y Cerveza del Conicet.
Un grupo de científicos integrantes del Ipatec (Instituto Andino Patagónico de Tecnologías Biológicas y Geoambientales) detectó una baja de microorganismos contaminantes en las cervezas artesanales. El estudio se realizó en 15 cervecerías artesanales de Río Negro y Chubut que emplean la levadura patagónica Euby.
Registrate gratis
Disfrutá de nuestros contenidos y entretenimiento
Suscribite por $1500 ¿Ya estás suscripto? Ingresá ahora
Comentarios
Estimados/as lectores de Río Negro estamos trabajando en un módulo de comentarios propio. En breve estará habilitada la opción de comentar en notas nuevamente. Mientras tanto, te dejamos espacio para que puedas hacernos llegar tu comentario.
Gracias y disculpas por las molestias.
Comentar